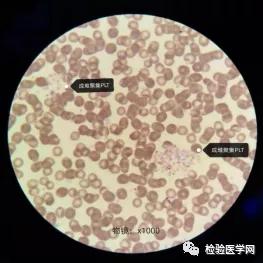
“秒”看血小板聚集，你get到了吗？

作者:河北医科大学第二医院上庄分院 孙海燕
审核:河北医科大学第二医院 杨洪乐
一、前 言
对于检验工作者来说,血常规日常复检工作中,每天因血小板问题触发复检规则,进行血涂片染色人工复检的标本大约占30%左右,给临床检验工作者带来困惑。既要染色又要使用显微镜观察血涂片报告复检结果,即使使用快速染色方法也需要10-20分才能报告结果,那么有没有一种快速、简便、准确的方法呢?
笔者综合了论文、公众号文章、工作实际发现了一种不需要染色血涂片的方法,即可通过显微镜报告复检结果。 这种方法具备不染色、节约试剂、节约时间、快速简便等优点。 下面随笔者结合实际案例了解一下这种“神奇”的方法吧。
不染色血涂片复检方法 ,也可称为白片法、未染色干片法,将制作好的血涂片在空气中迅速干燥,在显微镜下用低倍镜、高倍镜、油镜观察形态。本法适用于复检标本凝集、血小板聚集、冷凝集、PTCP(EDTA依赖性假性血小板减少)、血小板卫星现象等内容,几分钟即可报告结果。笔者也和染色方法做了相关比对和验证,结果显示一致。

二、血小板复检案例分析
我院门诊临检组使用贝克曼UniCel® DxH 800 Coulter®血液分析仪进行日常血常规检测。如何在标本量巨大的情况下,快速准确、高效识别血小板聚集,排除、纠正假阴性和假阳性,给临床提供可靠准确的检验结果,制定精准治疗方案,显得尤为重要,同时也是身为检验医师的我不懈努力的目标。
在众多的仪器报警中,“Platelet Clumps”或“血小板聚集”报警复检的占半数左右。下面就让我们结合案例给大家解释清楚吧。
案例1





从LIS结果中我们不难看出,仪器异常信息提示:Platelet Clumps,结合WBC直方图淋巴细胞群峰左侧有一异常小的波峰,触发复检规则,结合患者年龄,高度怀疑标本采集所致凝集。
再次检查标本状态,无血少,无肉眼可见凝块,推片复检。取血5-10ul全血制片,速干,1张染色,1张未染色,干燥后低倍镜和油镜人工镜检,显示标本凝集。从2张血涂片中均发现有凝集后的纤维蛋白丝,形状不同,有时会有很多血小板挂在边缘。笔者把之形象的形容为没有水的河道,曲曲弯弯,非常漂亮。
检验人员执行标本拒收程序将标本退回,通知患者重新采集标本。
案例2

同上,仪器提示Platelet Clumps,随即制片,染色,显微镜人工复检(约35min,中间没有任何耽搁)显示血小板聚集,在片中及片尾可见成堆血小板聚集。另外在WBC直方图上也出现了异常,在横坐标起点位置出现一个小的波峰,疑为成团血小板影响所致。此例案例怀疑为EDTA-PTCP,于是检验人员通知临床,建议更换抗凝剂重新采血。
重点来了,自发现仪器报警“Platelet Clumps”,从推片至染色完成,到复检报告,大概用时40min。 曾经有文献提到,使用不染色的干片暗视野高倍镜镜检或滴加0.9%等渗生理盐水加盖玻片高倍镜湿片镜检的方法,可快速检测出体外血小板聚集。 由于湿片还需盖玻片或改良牛鲍计数盘的消耗,没有优先考虑。
在杨老师的指导下,经过数次数个此类标本的染色和不染色的对比,最终得出干片不染色法可行性极强的结论,从发现异常报警到报告结果约需要10 min,甚至2-5分钟即可报告,大大节约了复检时间。 但是对PLT,WBC以及RBC的形态学检测,瑞-姬氏染色仍是唯一的金标准。
三、总结
血常规是检验工作中最基础、最普及的检测项目,但小小的血常规却是疾病诊断的重要依据。 把控好临床检验前、检验中、检验后的层层质量关至关重要! 在仪器给我们检验带来高效率、高速度,高精准性的同时,我们仍不能忽视复检规则,应具体问题,具体分析。对于本职业知识的不断学习与积累,博采众长,取他人之长,补自己之短,在实践中发现乐趣,追求精益求精,总结经验,给予临床和患者做出贡献,实现自己的人生价值,这是检验人之根本所在。
最后一句是经验丰富的李彦会老师对我的告诫语:要时刻鞭策自己,因为学习如逆水行舟,不进则退。
经过不断的实验和总结,认为有三点需要大家注意:
第一点,严格按照sop制定的复检规则进行复检,不应有偷懒或者懈怠行为,因为这关系到患者的诊断和治疗,关系到检验的结果是否准确。以上2个案例血小板数值均未发现减低,但均触发复检规则。
第二点,利用白片法进行血小板复检时,一定要注意降低聚光器、调小光圈、调暗灯的亮度,也就是我们所说的暗视野,再用低倍镜、高倍镜和油镜下依次进行观察。否则我们看不到精彩的镜下影像。
第三点,本方法只应用于血液凝集、PTCP、冷凝集等异常的发现,对于血小板形态上的异常依然依靠瑞姬染色(或瑞氏染色)识别。
“秒”看血小板聚集,你get到了吗?
希望能给大家带来些许帮助和便捷,
不妨试一试吧。
来源:检验医学网